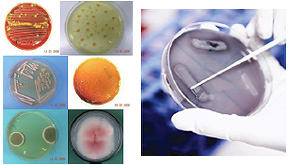
Preparation

AXIMA Microorganism Identification System - Features
Just three steps from sample preparation to identification
Sample Preparation
Prepare a microorganism colony (or culture fluid).
No prior gram staining or morphological evaluation is required. No specialized experience or background knowledge about microorganisms is required. Analysis is possible with a few micrograms of sample containing approximately 105 bacteria. As a single colony can be analyzed, colonies derived from multiple bacterial strains on the agar medium do not hinder analysis.
Step 1

Apply the collected bacteria sample and matrix reagent to a special MALDI plate.
The basic sample preparation method is extremely simple: just mix the bacteria sample and matrix reagent on the MALDI plate*1.
The disposable MALDI plates simplifies handling. You can choose from the preexisting optimal sample preparation methods (protocols) according to your needs.
Step 2

Measure using MALDI-TOF MS. The unique mass spectrum for the bacterial species is rapidly obtained.
Measurements are conducted automatically, using existing methods. No mass spectrometry experience is required. It is not necessary to check each mass spectrum.
Step 3

Check the acquired mass spectrum against the spectrum databases registered in the analysis software to classify and identify the microorganism.
The entire sequence of operations from database searching to displaying the identification results is automated. No parameter adjustments are required.
Reliable databases
The reliable databases provide powerful support for microorganism identification.
Unrivalled comprehensive microorganism database

Fully validated spectrum database
SuperSpectraTM Number of registered mass spectra*2: 2,000 min.
SuperSpectraTM contains peak groups that can act as markers to offer stable detection of commonly detected bacterial species under multiple conditions. These marker peak groups are extracted from at least 15 mass spectra for each microorganism strain that are obtained at multiple laboratories under many measurement conditions. It produces reliable identification results under most conditions.
The identification of microorganisms by MALDI-TOF MS previously suffered from problems with mass-spectrum reproducibility. However, SuperSpectraTM overcomes these problems to significantly reduce errors during the identification of the microorganisms. SuperSpectraTM and other databases contain approximately 40,000 mass spectra. Databases can be supplied even for rarely detected bacterial species.
Database customization to support all fields

It is easy to register a new microorganism in the database. Operations to extract the peak groups that can act as markers from multiple mass spectra are simple and intuitive. This allows the user to rapidly develop a high-quality database.
*1 Always inactivate infectious or possibly infectious samples before handling.
*2 The total number of mass spectra may change due to database optimization.
Provides better discrimination capabilities
Strain Solution (option)
Highly-accurate Bacterial Characterization Using Fast and Simple MALDI-TOF MS
Strain Solution software uses a MALDI-TOF mass spectrometer, based on the S10-GERMS method, to discriminate bacteria at subspecies or strain level.
The bacteria can be characterized by preregistering markers that allow the user to differentiate the subspecies and strains of bacteria. Subsequently, these markers are matched to the MALDI-TOF MS measurement data to determine the target bacteria strain.
Features
- Obtain more precise and reliable discrimination results than conventional microorganism identification methods using MALDI-TOF-MS fingerprinting.
- Quickly characterize bacteria by genetic differences in the base sequence using MALDI-TOF MS.
- Create and customize bacterial strain databases.
- Perform molecular phylogenetic analysis using external software.
Applications
The software broadens the range of possible applications using the AXIMA-iD Plus Microorganism Identification System by enabling bacterial characterization down to the strain level. This software is ideally suited for:
- Management of bacterial culture collection
- Discrimination of genetically similar bacteria that are difficult to differentiate by 16S rRNA gene sequencing
- Molecular phylogenetic analysis
S10-GERMS* Method
The S10-GERMS method links ribosomal protein molecular weight information obtained using MALDI-TOF MS to genetic information to classify and identify microorganisms. Focusing on the S10-spc-alpha operon, for which about half the ribosomal proteins are coded, enables genetic information to be associated with molecular weight information from MALDI-TOF MS, even for non-genome sequenced bacterial species.
* S10-GERMS: S10-spc-alpha operon Gene Encoded Ribosormal protein Mass Spectrum

Figure: Example of Discriminating Bacterial Strains with 99.9 % 16S rRNA Gene Homology Using the S10-GERMS Method
Workflow Using Strain Solution

1. Portions indicated in “obtain the theoretical mass of ribosomal protein” indicate functionality not included in the software.
2. The software does not include marker peaks registered for samples other than the test sample. Bacterial strain marker peaks for the target bacterial species must be registered in advance.


